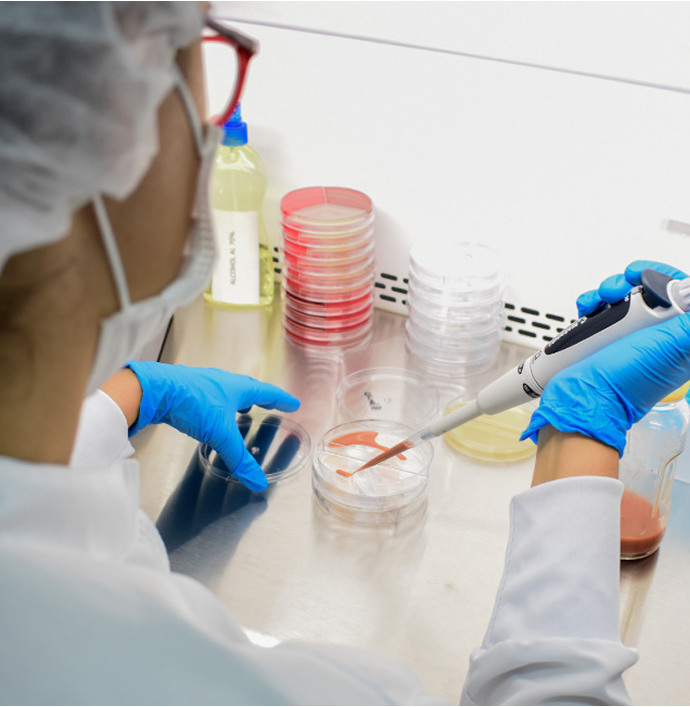

Nuestra historia comienza con la iniciativa de una empresaria colombiana, que decide crear una marca de cuidado del cabello con el nombre de «Cosméticos MYE». Para ello, contrata los servicios de terceros para la fabricación. Se inicia la venta en el mercado local, logrando una rápida aceptación por parte de los consumidores.

Aumenta el reconocimiento de la marca entre consumidores y nuestra red de distribuidores se expande a nivel regional.

Iniciamos producción en nuestra primera fábrica, con el objetivo de ampliar nuestro portafolio desarrollando productos de calidad.

Adquirimos una nueva sede con la tecnología y equipos necesarios para ampliar nuestra línea de producción, incorporando cosméticos faciales, cremas corporales y protectores solares. Actualmente es nuestra sede principal.

Adicionamos una nueva línea de servicios conocida como Maquila a terceros. Desde la formulación, producción y empacado, hasta el trámite de certificados e imagen de marca.

Logramos la consolidación en el territorio nacional e iniciamos procesos de exportación a Panamá y EE.UU.





• Shampoos <br>
• Cremas capilares<br>
• Acondicionadores<br>
•Tónicos • Geles • Aceites <br>
• Cremas capilares sin color <br>
• Tintes •Oxigentas <br>
• Tratamientos de alisado<br>
•Protectores térmicos <br>
• Cremas capilares con color

•Polvos compactos <br>
• Rubores <br>
• Maquilaje de ojos <br>
•Pestañinas <br>
• Delineadores de ojos<br>
• Labiales en barra<br>
• Esmaltes de uñas<br>
• Removedores

• Cremas faciales hidratantes <br>
• Cremas faciales <br>
•Antiarrugas <br>
• Sérums <br>
• Tónicos faciales <br>
• Agua micelar <br>
• Cremas limpiadoras

• Shampoos <br>
• Acondicionadores <br>
• Tónicos <br>
• Geles <br>
para el cabello

• Perfumes • Colonias <br>
• Cremas • Aceites <br>
•Geles antibacteriales <br>
• Jabón líquido <br>
• Alcohol antiséptico <br>
• Geles corporales <br>
• Gel frío • Espumas

• Shampoo <br>
• Rinse <br>
• Baños líquidos <br>
• Cremas <br>
•Antipañalíticas
$ 3.273
$ 2.945
$ 3.403 $ 3.063
$ 6.545
$ 7.069
$ 10.210 $ 9.189
$ 15.054
$ 15.708
$ 16.363
$ 16.363
$ 16.363
$ 20.250
$ 20.944 $ 18.850


Nuestra historia comienza con la iniciativa de una empresaria colombiana, que decide crear una marca de cuidado del cabello con el nombre de «Cosméticos MYE». Para ello, contrata los servicios de terceros para la fabricación. Se inicia la venta en el mercado local, logrando una rápida aceptación por parte de los consumidores.

Aumenta el reconocimiento de la marca entre consumidores y nuestra red de distribuidores se expande a nivel regional.

Iniciamos producción en nuestra primera fábrica, con el objetivo de ampliar nuestro portafolio desarrollando productos de calidad.

Adquirimos una nueva sede con la tecnología y equipos necesarios para ampliar nuestra línea de producción, incorporando cosméticos faciales, cremas corporales y protectores solares. Actualmente es nuestra sede principal.

Adicionamos una nueva línea de servicios conocida como Maquila a terceros. Desde la formulación, producción y empacado, hasta el trámite de certificados e imagen de marca.

Logramos la consolidación en el territorio nacional e iniciamos procesos de exportación a Panamá y EE.UU.